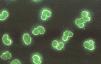
fig3

Durante los últimos años el avance tecnológico ha permitido desarrollar técnicas que ayudan al diagnóstico de múltiples enfermedades. En el caso de las enfermedades autoinmunes, las técnicas inmunológicas son de gran ayuda ya que permiten la detección de varios autoanticuerpos simultáneamente a partir de volúmenes de muestra pequeños. Aunado al desarrollo de las nuevas técnicas, la sensibilidad y especificidad en la detección de las especificidades de los anticuerpos también han ido en aumento, de tal manera que el clínico puede contar con pruebas que le permiten hacer los diagnósticos tempranos con mayor certeza y hacer también el seguimiento del curso de la enfermedad en función de la variación de los anticuerpos presentes en las muestras de los pacientes. Cabe destacar que las nuevas técnicas de laboratorio que se utilizan para el apoyo en el diagnóstico de las enfermedades autoinmunes ya no son exclusivas de laboratorios de investigación, sino que por su control de calidad, facilidad de estandarización y reproducibilidad pueden usarse en laboratorios clínicos medianos y pequeños. En el presente trabajo se describen las técnicas de mayor aplicación en el laboratorio clínico para enfermedades autoinmunes.
During the past few years technological advance have been allowed the developing of techniques that help to the diagnosis of multiple diseases. In the case of the autoimmune diseases, immunological techniques are helpful since they allow the detection of multiple autoantibodies at the same time with small volumes of sample. Together with the development of the new techniques, sensitivity and specificity in the detection of the antibodies specificities’ also have been increased, in such a way that the clinicians can count with tests that allow them to make early diagnoses with greater certainty and also to follow the course of the disease based on the variation of the antibodies presents in the patient's samples. It is important to emphasize that the new techniques of laboratory that are used for the support of the diagnosis of autoimmune diseases, no longer are exclusive for research laboratories but by their facility of standardization, quality control and reproducibility they can be used in clinical laboratory of medium and small sizes. In the present paper we describe those techniques with greater application in the clinical laboratory of autoimmune diseases.
Desde la descripción de Hargraves del fenómeno de las células LE y su asociación con el lupus eritematoso generalizado (LEG), el estudio de los anticuerpos asociados a las enfermedades autoinmunes cobró gran importancia. Actualmente, el apoyo por el laboratorio para el diagnóstico de las enfermedades autoinmunes consiste en un gran número de técnicas que permiten tanto identificar como confirmar el o los antígeno(s) específicos reconocidos. Además, este tipo de técnicas han evolucionado de manera importante en las últimas décadas, ya que se han desarrollado pruebas con mayor especificidad y sensibilidad. Entre las técnicas más utilizadas se encuentran: la inmunofluorescencia indirecta (IFI), el ensayo inmunoenzimático (ELISA), el ensayo múltiple y la electroinmunotransferencia (EIT). Cada una de ellas presenta diferencias pero conservan el fundamento general que es el reconocimiento de la unión antígeno-anticuerpo, por lo que presentamos las características más importantes de dichas pruebas.
Inmunofluorescencia indirectaLa inmunofluorescencia indirecta (IFI) es una de las técnicas más utilizadas en los estudios de autoinmunidad debido a su fácil manejo y estandarización. Sin embargo, la lectura e interpretación requieren de amplia experiencia. La técnica se basa en el reconocimiento de los anticuerpos que reconocen estructuras antigénicas celulares nativas. La interacción se evidencia por medio de un anticuerpo antiinmunoglobulina humana, producido en conejo, cabra o cobayo, dirigido contra las fracciones constantes (Fc) de las inmunoglobulinas IgG, IgA y/o IgM. Este anticuerpo antiinmunoglobulina humano está conjugado o acoplado a un fluoróforo (generalmente isotiocianato de fluoresceína [FITC]). Los resultados del reconocimiento de los antígenos por los autoanticuerpos presentes en el suero, plasma o cualquier otro líquido, se evalúan en un microscopio de epifluorescencia. Actualmente, la IFI se utiliza en los estudios de autoinmunidad para la detección de anticuerpos anti-DNA de doble cadena (DNAcd) o DNA nativo (DNAn) utilizando como sustrato Crithidia luciliae. Para la detección de anticuerpos que reconocen antígenos nucleares se utilizan como sustratos líneas celulares epiteliales humanas como las células HEp-2 o las células HeLa. En el caso de los anticuerpos contra componentes de los gránulos primarios y específicos de los polimorfonucleares o anticuerpos anticitoplasma de neutrófilos (ANCA), se utilizan neutrófilos fijados con etanol y formalina; y para los anticuerpos que reconocen antígenos órgano-específicos, se utilizan como sustratos cortes de tejidos específicos (v. g. tiroides, esófago, estómago, glándulas suprarrenales, glándulas salivales, etc.).
Detección de anticuerpos antiI-DNAn con Crithidia luciliae como sustratoEl ensayo se fundamenta en el reconocimiento de los anticuerpos que reaccionan contra el DNAn de la mitocondria gigante (cinetoplasto) del parásito Crithidia luciliae1. La prueba solo se considera positiva cuando se tiñe el cinetoplasto independientemente de la tinción en el núcleo, debido a que en el núcleo puede existir reactividad contra otros componentes, lo que da resultados falsos positivos. La técnica es altamente específica, pero poco sensible, por lo que es conveniente en ciertos casos confirmar los resultados con otras pruebas más sensibles como el ELISA.
Anticuerpos antinuclearesLa identificación y cuantificación de los anticuerpos antinucleares (ANA) no solo incluye antígenos que se localizan en el núcleo de células HEp-2, sino también antígenos del citoplasma. La importancia de usar células HEp-2 como sustrato se fundamenta principalmente en que tienen un núcleo más grande de lo normal debido a su gran cantidad de antígenos nucleares (v. g. más de 46 cromosomas, más de 3 nucleolos, abundantes ribonucleoproteínas, etc.) y citoplásmicos (v. g. mitocondrias, lisosomas, ribosomas, etc.) lo que permite hacer una fácil detección e identificación de los antígenos reconocidos por los autoanticuerpos presentes en los sueros de los pacientes con enfermedades autoinmunes. Además, por ser una línea celular muy activa, se pueden observar todas las fases del ciclo celular en los cultivos, con lo que se facilita la identificación de antígenos presentes solo en las fases de división, como los centrómeros o aquellos conocidos como proliferating cell nuclear antigens (PCNA) La detección de ANA mediante IFI utilizando como sustrato células HEp-2 es útil como prueba de tamizado inicial, debido a que los patrones de tinción más comunes se relacionan con una gran variedad de antígenos (tabla 1); sin embargo, resulta necesario realizar pruebas más sensibles y específicas como el ELISA para identificar el antígeno o antígenos reconocidos por los autoanticuerpos. También se pueden observar patrones de tinción específicos para antígenos, como: proteínas de la lámina nuclear, centríolos, Jo-1 y Scl-70, en cuyos casos el patrón observado es de gran utilidad para identificar específicamente al antígeno reconocido, el cual puede ser confirmado mediante ELISA o EIT.
Antígenos reconocidos por los autoanticuerpos que dan los patrones de tinción de los ANA
| Patrón | Antígeno | |
| Nuclear | Homogéneo | DNAcd, histonas, Ku |
| Moteado grueso | RNP, Sm, Scl-70, SSB, RNA | |
| Perinuclear | DNAcd, DNAcs | |
| Ciclo celular | Nucleolar | RNA, RNP |
| Citoplásmico | Citoplásmico | SSA, Clatrina |
| Mitocondrial | Mitocondriales, fosfolípidos de la mitocondria | |
| Filamentos intermedios | Vimentina, actina, desmina, etc. |
DNAcd: DNA de cadena doble; DNAcs: DNA de cadena sencilla; RNP: ribonucleoproteínas.
Para la detección de los ANCA, la IFI se utiliza también como prueba de tamizado inicial, debido a que en ella se observan los 3 patrones de tinción que se relacionan con manifestaciones clínicas de autoinmunidad. Los patrones son: el citoplásmico o cANCA, el perinuclear o pANCA y el atípico o xANCA. El patrón cANCA se caracteriza por presentar una tinción citoplásmica en neutrófilos fijados con etanol o acetona. Los anticuerpos que dan el patrón cANCA reconocen proteínas débilmente catiónicas o neutras como la proteinasa-3 (PR-3) y la proteína catiónica de 57kDa (CAP-57), las cuales se liberan de los gránulos específicos por el tratamiento de las células con alcohol o acetona y se distribuyen de manera homogénea en el citoplasma de los neutrófilos (fig. 1).
El patrón pANCA se observa en neutrófilos fijados con etanol o acetona y es perinuclear homogéneo. El patrón está dado por los anticuerpos que reconocen proteínas fuertemente catiónicas como: mieloperoxidasa (MPO), elastasa y azurocidina, las cuales cuando son liberadas de los gránulos primarios y específicos del neutrófilo se reorganizan en la periferia del núcleo, el cual tiene carga negativa por el DNA (fig. 2A). El patrón pANCA se debe confirmar en neutrófilos fijados con formalina. La formalina es un solvente orgánico que reduce el efecto de atracción de las proteínas catiónicas (MPO, elastasa y azurocidina) hacia el DNA, con lo que quedan distribuidas en el citoplasma. Los anticuerpos que las reconocen dan un patrón citoplásmico en la IFI (fig. 2B).
Patrón pANCA. A) Los anticuerpos que reconocen las proteínas fuertemente catiónicas mieloperoxidasa (MPO) elastasa y azuricidina dan el patrón periférico del núcleo en neutrófilos fijados con alcohol o acetona. B) Estos mismos anticuerpos cuando se prueban en neutrófilos fijados con formalina dan un patrón citoplásmico.
El patrón xANCA o atípico es el resultado del reconocimiento de las proteínas: catepsina G, lisozima y lactoferrina. Dichas proteínas se liberan de los gránulos específicos de los neutrófilos y se redistribuyen en la periferia del núcleo cuando son tratados con etanol, acetona o formalina. Es importante enfatizar que el efecto de reacomodo perinuclear de las proteínas mencionadas no se ve modificado en los neutrófilos fijados con formalina (fig. 3). Por ser un patrón perinuclear se puede confundir con el patrón pANCA, por lo que es importante estudiar las muestras de los pacientes que presentan dicho patrón en neutrófilos fijados con alcohol o acetona y en neutrófilos fijados con formalina.
Anticuerpos órgano específicoMediante IFI se identifica la reactividad de los autoanticuerpos presentes en las muestras de pacientes con enfermedades autoinmunes, los cuales reconocen antígenos específicos de determinados órganos. Para caracterizar el o los antígenos específicos reconocidos por los anticuerpos, es necesario utilizar ELISA que contienen los antígenos específicos. Para la detección de anticuerpos órgano específico, se emplean laminillas que contienen cortes de tejidos de órganos, en su mayoría de primates. Entre estos cortes se cuentan: glándulas adrenales, músculo cardiaco, esófago (para identificar anticuerpos antiendomisio), riñón (para identificar anticuerpos antimembrana basal glomerular) y páncreas (para identificar anticuerpos anticélulas de los islotes pancreáticos).
Ensayo inmunoenzimáticoComo se mencionó anteriormente, el ELISA es una de las técnicas más utilizadas para identificar o confirmar la especificidad de los anticuerpos presentes en las muestras de los pacientes con enfermedades autoinmunes. Además, por su fácil estandarización, manejo y variedad de antígenos disponibles, ha desplazado notablemente a otras técnicas como el radioinmunoensayo para la detección de anticuerpos anti-DNAcd (conocido también como prueba de Farr), ya que no utiliza radionúclidos, lo que hace que sea una técnica accesible y de bajo riesgo. Si bien existen diferentes tipos de ELISA, el más utilizado en el laboratorio de diagnóstico de autoinmunidad es el ELISA indirecto, el cual se fundamenta en el reconocimiento de los anticuerpos específicos presentes en las muestras de los pacientes, mediante un anticuerpo dirigido contra la región Fc humana de cualquier isotipo (IgG, IgA o IgM) e inclusive de cualquier subclase (IgG1, IgG2, IgG3, IgG4, IgA1 o IgA2). Los anticuerpos anti-Fc están unidos a enzimas como la peroxidasa o la fosfatasa alcalina. Los antígenos utilizados en las placas de ELISA pueden ser nativos, recombinantes (antígeno completo o epítopo específico) o sintéticos (epítopo específico). Después de permitir la interacción de los anticuerpos de las muestras de los pacientes con el antígeno pegado a la placa de ELISA, se realizan lavados para eliminar los anticuerpos inespecíficos y se agrega el anticuerpo antiinmunoglobulina humana unido a enzima, permitiendo la interacción por un tiempo determinado. Posteriormente, se adiciona la solución que contiene el sustrato-cromogénico específico de la enzima (3, 3′, 5, 5′-Tetrametilbenzidina [TMB] para la peroxidasa o p-nitrofenilfosfato para la fosfatasa alcalina) el cual cambiará de color en función de la cantidad de anticuerpos conjugados con la enzima y cuya cantidad depende de los anticuerpos del paciente que reconocieron al antígeno pegado a la placa. En otras palabras, la intensidad de coloración es directamente proporcional a la cantidad de anticuerpo del paciente unido al antígeno3 (fig. 4). La técnica puede ser cualitativa si solo se requiere conocer si existen o no anticuerpos con reactividad por determinado antígeno o cuantitativa si se requiere conocer la cantidad de anticuerpos presentes en las muestras, para lo cual el ensayo debe incluir una curva patrón de reactividad especifica. El ELISA tiene como ventaja que no se necesita un equipo sofisticado para su lectura.
ELISA. La placa de 96 pozos se recubre con antígenos específico, los cuales son reconocidos por los anticuerpos presentes en los sueros de los pacientes. La unión se revela cuando se adiciona un anticuerpo anti-Fc humana conjugado con una enzima. Al agregar el sustrato de la enzima cambia de color el medio.
En los últimos años el ensayo luminométrico múltiple (ELM) se ha vuelto popular, debido a que permite la detección de hasta 100 diferentes autoanticuerpos que reconocen el mismo número de antígenos en una sola determinación y con un volumen pequeño de muestra (aproximadamente 50μL). Estas son las ventajas más importantes del ensayo comparado con el ELISA, ya que para realizar el mismo número de determinaciones específicas por ELISA se requerirían 100 placas y 5mL de muestra. La técnica es una variante del ELISA indirecto, pero la detección es distinta: en el ELISA se utiliza un compuesto cromogénico, en tanto que en el ELM la detección se realiza por fluorescencia, con lo que la sensibilidad del ensayo es mayor. El ELM se fundamenta en la detección de anticuerpos que reaccionan contra antígenos específicos, los cuales recubren esferas que contienen diferentes proporciones de un fluoróforo (combinaciones de un fluoruro rojo y otro infrarrojo). La determinación de la cantidad de anticuerpo unido al antígeno se revela por la interacción de un anticuerpo anti-inmunoglobulina humana conjugado con biotina. Posteriormente, se adiciona un conjugado estreptavidina-ficoeritrina (PE). El ensayo se lee en un luminómetro, instrumento que tiene el mismo principio que el citómetro de flujo. De manera breve, cuando se hacen pasar por un detector de fluorescencia, las microesferas que contienen los complejos antígeno-anticuerpo-estreptavidina-PE, el colorante de las microesferas y la PE se excitan por haces de luz de longitudes de onda de 635 y 488nm respectivamente. La luz del láser que pasa por el filtro de longitud de onda de 635nm excita al fluoróforo de la microesfera, lo que permite la identificación de los antígenos y el láser que pasa por el filtro de 488nm excita a la PE conjugada con estreptavidina, permitiendo la detección de la cantidad de anticuerpo específico presente en la muestra del paciente (fig. 5)2,4.
Ensayo luminométrico múltiple. Las microesferas recubiertas con antígenos específicos son reconocidas por los anticuerpos presentes en el suero de pacientes. La interacción antígeno-anticuerpo se revela por la formación de un complejo anticuerpo anti-Fc humana-estreptavidina-PE el cual al pasar por el detector del equipo de luminometría es excitado por un láser que pasa por 2 filtros: uno de 635nm, que permite discriminar entre perlas y otro de 488nm, que permite cuantificar la intensidad media de fluorescencia, es decir, la unión de los anticuerpos del paciente al antígeno.
La EIT, junto con el ELISA y el ELM son las técnicas de mayor sensibilidad y especificidad para la detección de anticuerpos contra antígenos específicos; sin embargo, la EIT tiene la desventaja de ser cualitativa o semicuantitativa. Se fundamenta en el reconocimiento de anticuerpos que tienen especificidad por antígenos que se absorben en una membrana (de nitrocelulosa o nylon). Los antígenos adsorbidos en la membrana fueron previamente separados en geles de poliacrilamida-dodecil sulfato de sodio (PAGE-SDS) y transferidos a las membranas. La unión de los anticuerpos a los antígenos específicos se detecta mediante la adición de un anticuerpo que reconoce la región Fc de las inmunoglobulinas humanas, el cual está acoplado a una enzima (fosfatasa alcalina o peroxidasa). La unión se revela con la adición de un sustrato-cromogénico soluble (alfa-naftol/Fast red o NBT/BCIP [cloruro de azul de tretrasodio/sal de toluidina de 5-bromo-4-cloro-3-indolfosfato], para cada enzima, respectivamente) el cual se precipita en el sitio en donde se encuentra el complejo antígeno-anticuerpo por la acción de la enzima. La EIT es una técnica accesible y de fácil interpretación ya que no requiere de ningún instrumento para su lectura, pues se hace de forma visual6.
Nanoensayo luminométrico múltipleEl nanoensayo luminométrico múltiple (NALIA) es uno de los métodos de detección múltiple de reciente desarrollo. Permite identificar la reactividad simultánea contra 10 autoantígenos. Es una técnica que deriva de la EIT y se fundamenta en el reconocimiento de autoantígenos adsorbidos en pequeñas cantidades o puntos, en placas de 96 pozos de ELISA con fondo de membrana de nitrocelulosa. El complejo antígeno-anticuerpos se detecta por medio de un segundo anticuerpo que reconoce la región Fc de las inmunoglobulinas humanas, el cual esta conjugado con un fluoróforo. La reactividad se mide por medio de un analizador de imágenes5. La técnica es cualitativa y requiere de un instrumento lector y de un programa de computadora para su interpretación (fig. 6).
Imagen que muestra una placa del nanoensayo luminométrico múltiple o NALIA (parte superior). En la parte inferior de la imagen se esquematiza un pozo; como se puede ver cada pozo contiene 10 antígenos y 2 controles por duplicado. Los antígenos se muestran en la parte inferior derecha de la imagen. Los controles, localizados en la parte media del pozo son: amortiguador o buffer (control negativo) y albúmina sérica humana unida a biotina (Biotin-HSA, control positivo del sistema). McBride, 2008.
- •
La IFI es una técnica de tamizado inicial que, de acuerdo a los sustratos utilizados (células HEp-2, neutrófilos o tejidos) permite identificar los posibles antígenos reconocidos por los autoanticuerpos presentes en los sueros de los pacientes con enfermedades autoinmunes.
- •
Entre las técnicas inmunológicas que apoyan al diagnóstico de las enfermedades autoinmunes se cuenta la IFI, el ELISA, la EIT y los ensayos múltiples (ELM y NALIA).
- •
El ELISA, la EIT y los ELM son pruebas confirmatorias de la reactividad de los anticuerpos presentes en las muestras de pacientes. Su sensibilidad y especificidad son mayores comparadas con las pruebas de tamizado inicial.
Los autores declaran no tener ningún conflicto de intereses.
Nota: Sección acreditada por el SEAFORMEC con 1,7 créditos. Consultar preguntas de cada artículo en: URL: http://reumatologíaclínica.org.